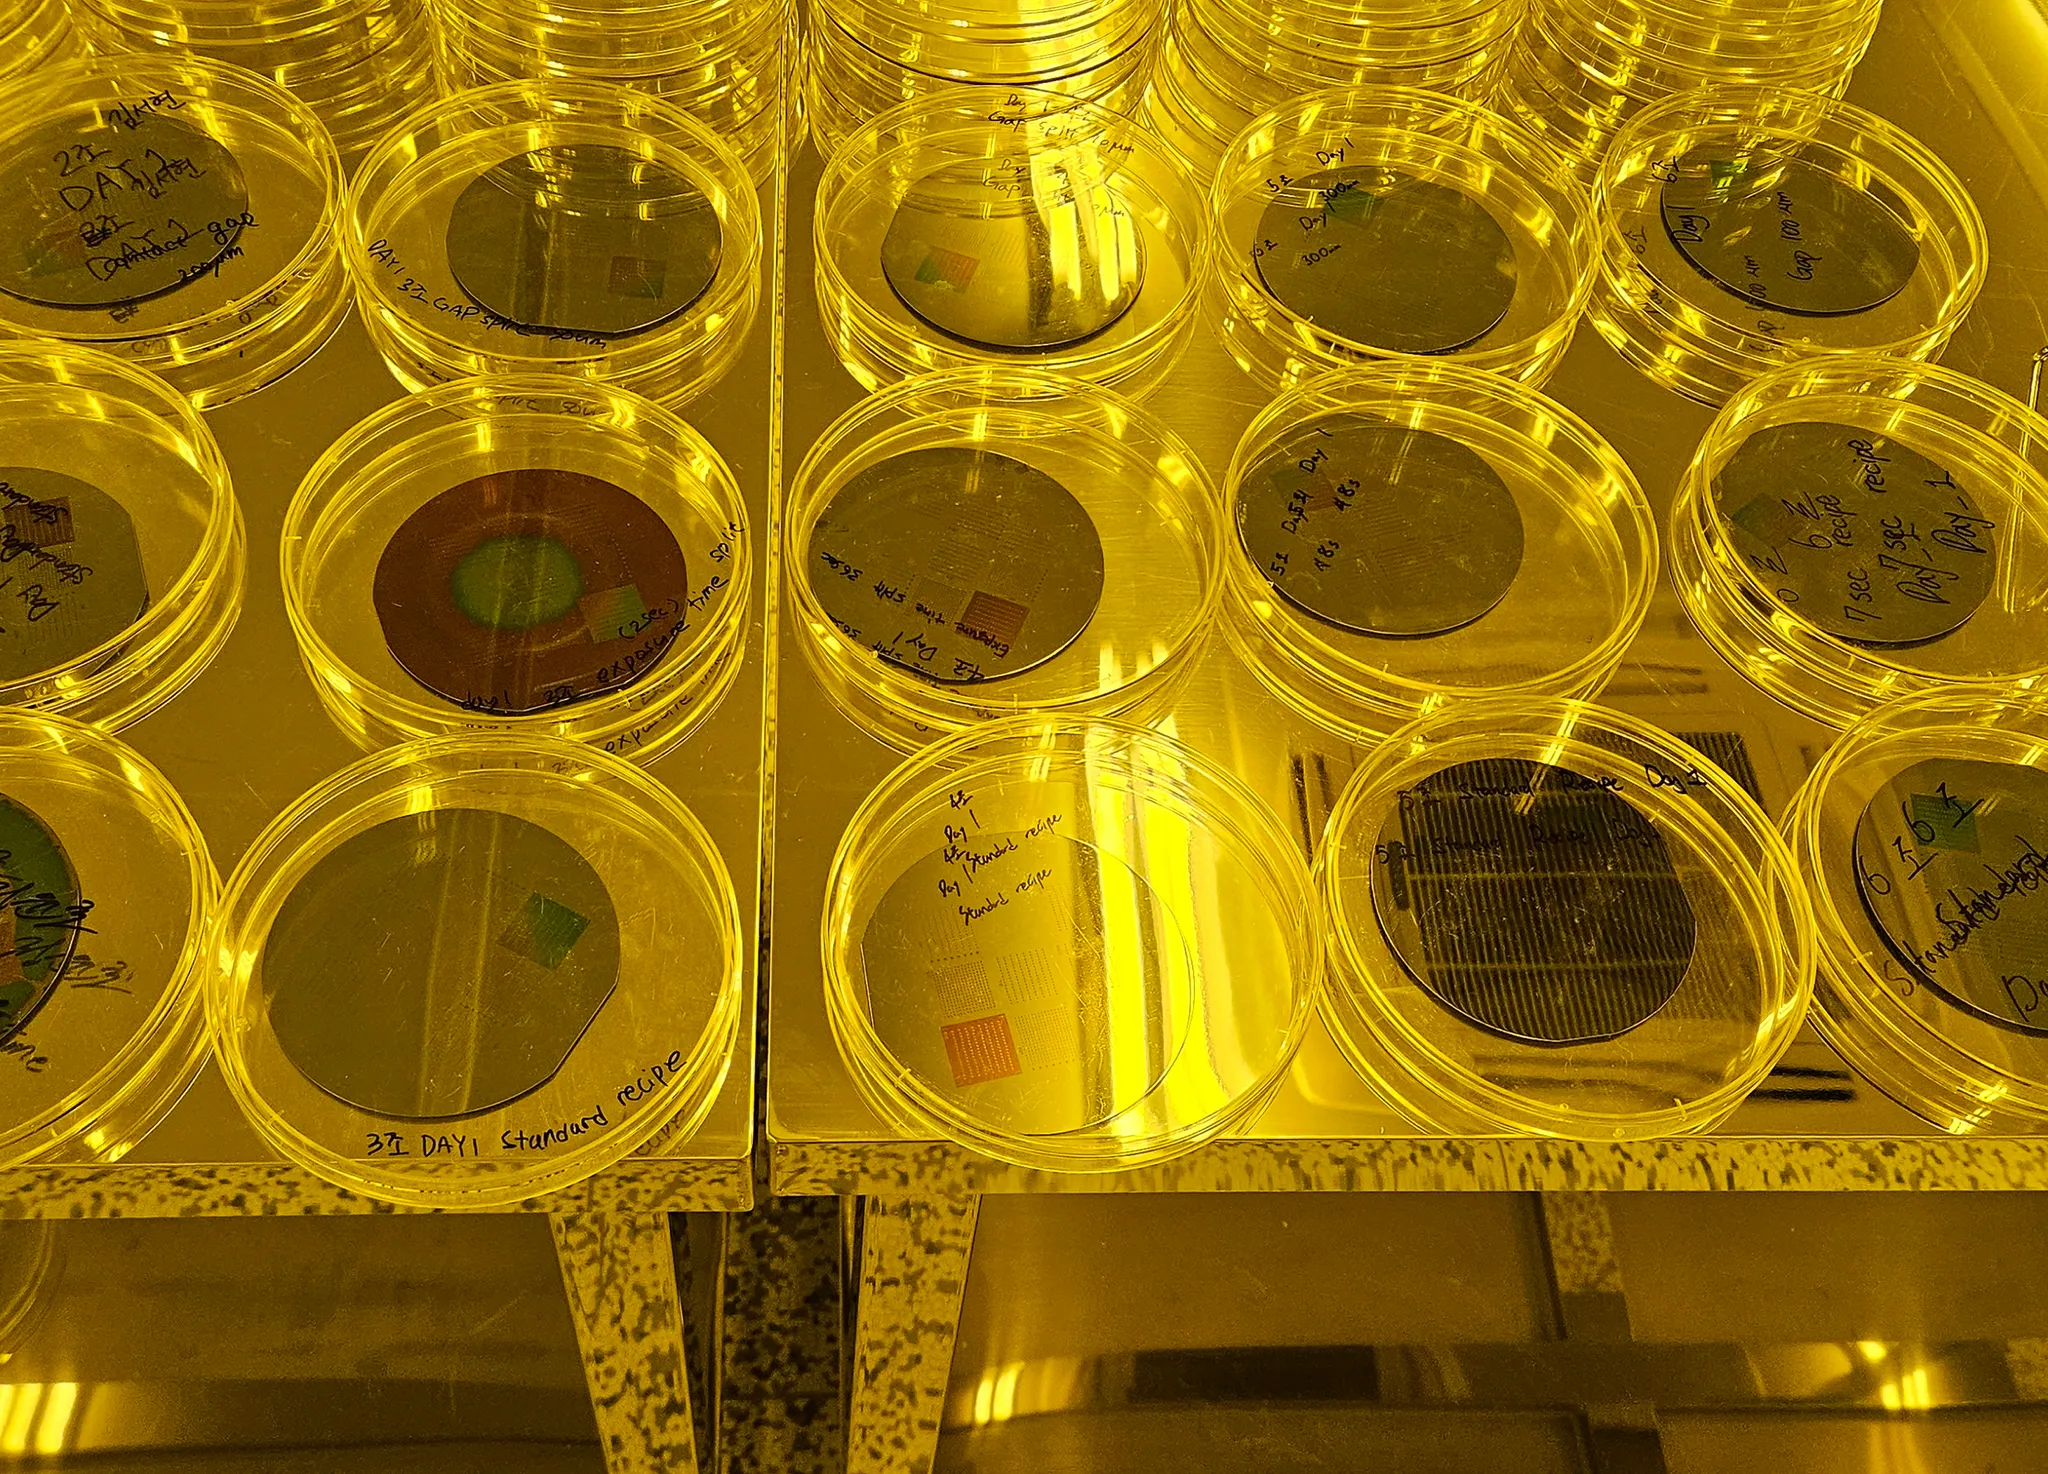

우리는 지금 'ChatGPT'로 시작된 AI 혁명, 그 거대한 소용돌이의 한가운데 서 있습니다. 그리고 이 변화의 한복판에는 HBM과 AI 반도체라는 강력한 엔진이 뛰고 있습니다.
지금 이 분야는 막 꽃을 피우기 시작한 ‘개화기’입니다. 모든 정보가 폭포수처럼 쏟아지고, 어제 배운 기술이 오늘 낡은 것이 될 만큼 세상은 빠르게 변합니다.
이 새로운 길 위에서 우리는 성공보다 실패나 혼란을 먼저 마주할지도 모릅니다. 하지만 두려워하지 마세요.
“성공이 최종적인 것은 아니다. 실패가 치명적인 것도 아니다. 오로지 계속되는 용기만이 중요하다.” — 윈스턴 처칠
이 메시지는 거대한 물결 속에서 자신의 커리어를 고민중인 여러분에게 꼭 필요한 말입니다.
김박사넷 반도체 아카데미는 도전을 선택한 여러분과 함께 ‘계속되는 용기'를 추구합니다. 이곳에서 시대의 흐름을 읽고 가장 빠르게 꿈을 현실로 만들어 보세요.
대학이 검증하고 인정하는 반도체/AI 교육 표준
국내 주요 대학교의 반도체 교육단이 김박사넷 반도체 아카데미의 커리큘럼을 도입했습니다. 기업들이 요구하는 역량을 지닌 학생들을 반도체 교육단과 함께 육성하고 있습니다.
김박사넷 반도체 아카데미
누적 수료생 800+명 |
학생 평균 만족도 4.7/5.0
교과서를 넘어, 현장의 속도를 따라잡는 실전 커리큘럼
AI가 촉발한 반도체 산업의 최신 흐름과 HBM & AI GPU 역공학 구조 분석, 포토 공정 실습, 엔비디아 인증서 발급까지- 기업이 필요로 하는 역량만 압축했습니다.
주요 교육 커리큘럼
HBM부터 AI 반도체까지, 교과서가 따라잡지 못하는 기술의 속도를 담았습니다. 지금 급변하는 시대에서 가장 필요로 하는 역량을 중심으로 설계된 로드맵입니다.
HBM & 엔비디아 GPU 역공학 구조 분석
비전공자도 이해할 수 있는 눈높이로 NVIDIA AI GPU와 HBM의 구조를 완벽하게 해부합니다. 단순 암기가 아닌, 반도체 산업의 기술 흐름을 꿰뚫는 통찰력을 기릅니다.
8대 공정(포토 공정) 이론 및 실습
책으로만 배운 포토 공정이 아닙니다. 실제 팹 환경에서 방진복을 입고 장비를 다루며 공정 변수를 조절해보는 엔지니어링을 경험합니다.
엔비디아 엣지 하드웨어 실습 (인증서 발급)
엔비디아 GPU 반도체를 활용해 Edge 시스템반도체에 의존하는 LLM 데이터를 분석합니다. 과정 수료 시 글로벌에서 인정받는 NVIDIA 공식 인증서를 발급합니다.
기업들이 인정한 아카데미 졸업생들의 역량
“김박사넷 반도체 아카데미 수료생들은 이곳에서 커리어를 시작했습니다”
졸업생들의 대부분은 삼성전자와 하이닉스에서 커리어를 시작했으며, HBM 제조를 포함한 AI 반도체 어드밴스드 패키징 회사에서 커리어를 지속적으로 계발하고 있습니다.
“선배들이 증명하는 교육의 효과”
아침에 일어나 16일 동안 오기 힘들었지만 힘들었던 만큼 얻어가는 부분도 많아 앞으로 제 학부생활에 도움이 많이 될 것 같습니다 원장님이 강조하셧던 부분들을 꼭 고려하고 정리하여 제 미래의 방향성에 반영하도록 하겠습니다! 이번 강의 힘들었지만 정말 유익했습니다! 감사했습니다 원장님 그리고 조교님들!!
학점이 낮아 전공에 대해서 회의감이 느껴지고 있을 때 정말 기적같이 찾아온 기회였습니다! 교육 덕분에 앞으로의 목표들을 세우고 나아가는 길에서 큰 도움이 된 것 같아 너무 좋았습니다!
HBM에 대해 기초적인 내용만 알고있었는데, 전공정부터 패키징 네트워킹까지 쉽게 이해가능하도록 수업을 해주셨습니다. 이제는 간단하게라도 HBM에 대해 설명할 수 있게 된 것 같아 감사합니다!
HBM에 대해서는 잘 배울 기회도 없었고, 감이 오지 않았습니다. 산업의 흐름부터 기술까지 설명해주셔서 잘 배웠습니다. 정말 감사합니다.
강의력이 좋으시고, HBM에 대해 구체적으로 알 수 있는 시간이었습니다. 이렇게 구체적으로 배울 수 있는 강의가 잘 없는데 이런 강의를 열어주셔서 감사드립니다. 기술적인 면에서도 깊이있게 파고들어서 좋았고, 그 뿐만 아니라 산업적인 면 등 더 넓은 시야를 강조해주셔서 너무 좋았습니다.
비록 2일이지만 많은 정보를 함양할 수 있었고, 패키징에 대한 내용을 함양하고 미래에는 어떤 기술이 쓰이므로 어떻게 준비하고 어떤 것에 대해 조사해야 되는지 알 수 있어서 좋았다. 이러한 정보 및 내용을 가지고 관련 회사를 찾거나 자소서, 면접 준비를 할 때 많은 도움이 될 것으로 추측된다. 심화 과정이나 그런 것이 있으면 나중에 신청하고 싶다.
Packaging에 대한 이론 내용만 알고있었을뿐 산업에 대한 전반적인 관점이나 자소서에 쓸 내용등에 대해서는 막막했었는데 덕분에 조금이나마 그 해답을 찾을수 있었던 유익한 강의였다고 생각합니다!
패키징 이론이 아니라 산업의 관점에서 AVP를 접근하여 이해하기 쉽고 자소서 작성 시 지원동기 부분에 도움이 많이 될 것 같다. 전반적으로 매우 만족한다.
리버스 엔지니어닝이라는 개념을 처음 접하고 적용해봄으로서 기업의 입장과 엔지니어가 가져야 하는 마인드에 대해 배웠습니다. 또한 산업군 현재 실태에 대해 잘 아시고 있어서 경향을 파악하는데 도움이 많이 되었습니다.
정말정말 유익한 시간이었습니다. 실제로 질문 올린 것을 수업 초장부터 답변을 해주셔서 너무 좋았고 쉬는시간에도 답변을 정성스럽게 해주셔서 감사하고 또 궁금증이 풀렸습니다
너무 도움이 됐습니다. 기술적인 부분 뿐만 아니라 전체적인 흐름과 배경에 대해 정리해주셔서, 면접 준비와 답변 방향 고민 시 큰 도움이 될 것 같습니다. 10만원이 아깝지 않은, 아니 더 비쌌어도 됐을 것 같을 정도로 만족스럽습니다. 너무너무 귀한 시간이었습니다 감사합니다!
AVP 관련해서 유튜브로만 찾아보며 정보를 찾기 매우 힘들고 이해도 안됐는데 이해 잘되게 설명해주셔서 감사합니다! 많은 정보를 얻을 수 있었어요.
두시간이 정말 빠르게 지나갔습니다. 설명을 정말 잘해주셔서 안들었으면 후회했을 것 같습니다 ㅜㅜ 머리에 정리가 되지 않았던 여러가지 개념들이 빠르게 정리 되었습니다.
문의하기
•
제휴 문의 이메일: lim@phdkim.net